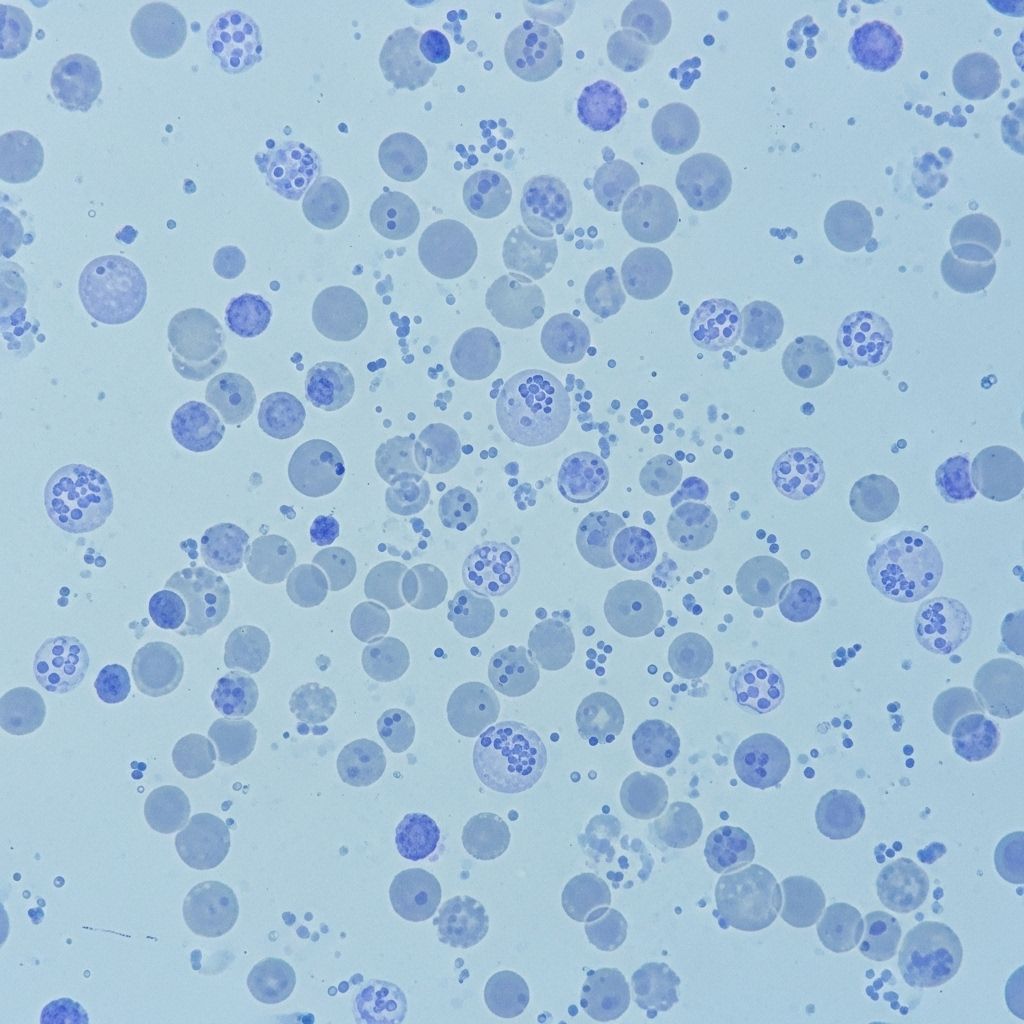

Understanding Leukemia White Blood Cell Count Ranges
Learn how white blood cell counts affect leukemia diagnosis, treatment, and overall health.
White blood cell (WBC) counts play a central role in the diagnosis, monitoring, and management of leukemia. The number and proportions of white blood cells in your blood can help experts identify cancer, track treatment effectiveness, and assess overall health risk factors. This article presents a comprehensive overview of leukemia’s impact on WBC counts, elucidates what normal and abnormal values mean, and addresses differences by age, sex, and health status.
What Is White Blood Cell Count?
White blood cells, also called leukocytes, are an essential part of the immune system, protecting the body from infections and foreign invaders. Your WBC count measures the number of these cells circulating in your bloodstream, typically expressed in cells per microliter (μl) of blood. WBC counts are a key part of the complete blood count (CBC) test, routinely performed in medical settings.
- Leukocytes: Infection-fighting cells.
- Red blood cells (erythrocytes): Carry oxygen throughout the body.
- Platelets: Help with blood clotting.
Normal White Blood Cell Count Ranges
Normal WBC ranges differ slightly based on age, sex, health, and laboratory standards. Below are commonly cited values for adults:
| WBC Count (cells/μl) | Red Cells (million/μl) | Platelets (per μl) | Hematocrit (%) | Hemoglobin (g/dL) | |
|---|---|---|---|---|---|
| Men | 5,000–10,000 | 4.7–6.1 | 150,000–400,000 | 42–52 | 14–18 |
| Women | 4,500–11,000 | 4.2–5.4 | 150,000–400,000 | 37–47 | 12–16 |
Laboratories may report slightly different reference ranges. Always compare results with the values provided by your lab.
Types of White Blood Cells and Their Normal Proportions
The WBC differential count provides percentages for different types of leukocytes in the blood:
- Neutrophils: 55–70%
- Lymphocytes: 20–40%
- Monocytes: 2–8%
- Eosinophils: 1–4%
- Basophils: 0.5–1%
- Band (young) neutrophils: 0–3%
These percentages indicate the relative abundance of each white blood cell type and help doctors interpret possible infections, immune disorders, and malignancies.
Absolute Neutrophil Count (ANC)
The absolute neutrophil count is calculated by multiplying the percentage of neutrophils by total WBC count. This value shows how well your body can fight bacterial infections:
- ANC < 1,000: Increased infection risk.
- ANC < 500: High risk, considered severe neutropenia.
White Blood Cell Counts in Leukemia
Leukemia disrupts normal blood cell formation in the bone marrow. Instead of making healthy cells, the marrow produces excessive abnormal WBCs that do not protect against infection. The genetic damage in leukemia leads to:
- Excessive numbers of abnormal WBCs
- Impaired function of produced WBCs
- Suppression of normal red cells and platelets formation
WBC Patterns by Leukemia Type
WBC counts can be much higher or lower than normal, depending on leukemia type and disease stage:
- Acute Lymphoblastic Leukemia (ALL)
- Acute Myeloid Leukemia (AML)
- Chronic Lymphocytic Leukemia (CLL)
- Chronic Myelogenous Leukemia (CML)
In acute leukemia, the best diagnostic sign is the presence of blasts in blood—immature, cancerous cells. If more than 20% of circulating cells are blasts, leukemia is highly likely. Sometimes, cancerous cells are trapped in bone marrow and absent in blood tests, leading to low WBC counts despite disease progression.
WBC Count Ranges in Children
Children’s blood counts vary significantly due to age-related factors. The Leukemia & Lymphoma Society provides reference values for pediatric patients:
- Newborns: 9,000–30,000 cells/μl
- Under age 2: 6,200–17,000 cells/μl
- Over age 2: 5,000–10,000 cells/μl
It is normal for young children (especially under age 4) to have a higher percentage of lymphocytes than adults. Leukemia is the most common cancer in kids and teens, predominantly seen as acute lymphocytic leukemia (ALL). Diagnosis often involves detecting high levels of lymphoblasts—immature lymphocytes—in blood or bone marrow, with over 20% indicating concern.
White Blood Cell Count and Cancer: What Does It Mean?
Elevated WBC counts can arise from various causes, not just cancer:
- Infections
- Autoimmune disorders
- Reactions to medication
- Leukemia
In leukemia, especially acute types, very high numbers of immature blasts signal malignancy. Some patients, however, show low WBCs if abnormal cells are primarily trapped in bone marrow.
Extremely High and Low White Blood Cell Counts in Leukemia
At diagnosis, people with leukemia may experience WBC counts dramatically outside normal limits:
- Extremely high: 100,000–400,000 cells/μl have been reported in certain cases.
- Very low: Results from suppression or entrapment of abnormal cells in the bone marrow.
Blood count trends during leukemia treatment are carefully monitored. A decrease in blasts is a sign of responding to therapy; an increase can signal relapse or resistance.
Other Blood Cell Count Changes in Leukemia
Besides WBCs, leukemia typically affects other blood components:
- Red Blood Cells: May drop, causing anemia.
- Platelets: Reduced numbers increase bleeding risk.
- Hematocrit & Hemoglobin: These decline due to anemia and suppressed healthy cell production.
White Blood Cell Counts in Pregnancy
Pregnancy physiologically elevates WBC counts. According to a 2021 study involving over 24,000 pregnant women:
- Total WBCs increase by 36%.
- Neutrophil count rises by 55%.
- Monocyte count rises by 38%.
- Lymphocytes decrease by 36%.
- Eosinophil and basophil counts remain unchanged.
This effect is normal in pregnancy and should not be confused with a disease process.
Diagnosing Leukemia: Beyond the CBC
While CBC and WBC differential are valuable screening tools, leukemia diagnosis requires additional confirmation. If leukemia is suspected, physicians may perform:
- Flow cytometry (analyzing cell types and markers)
- Bone marrow biopsy
- Genetic testing (identifying mutations and chromosomal abnormalities)
These specialized tests help identify the type of leukemia and devise a personalized treatment strategy.
Frequently Asked Questions (FAQs)
What is considered a dangerous white blood cell count in leukemia?
Counts below 1,000 (ANC) increase infection risk, while counts above 100,000–400,000 indicate severe disease activity or blast crisis in some types of leukemia.
Can other conditions cause abnormal WBC counts?
Yes. Besides leukemia, infections, autoimmune disorders, medication, and physiological states like pregnancy can change WBC counts.
What do blasts in the blood mean?
Blasts are immature cells. In leukemia, more than 20% blasts in blood or marrow suggest acute disease and warrant further investigation.
Do normal WBC counts always rule out leukemia?
No. Some leukemias trap abnormal cells in bone marrow, keeping WBC counts low in blood tests. Additional diagnostic procedures are needed for confirmation.
Why are multiple types of blood cells measured in leukemia?
Leukemia affects blood cell production globally. Red cells, platelets, and various WBC types are monitored to track disease status and treatment effects.
Conclusion
Understanding white blood cell count ranges is vital in leukemia diagnosis and management. Abnormal values—either high or low—can indicate serious disease and direct further testing, risk assessment, and therapy. Knowledge of these laboratory markers empowers patients, caregivers, and clinicians alike.
- Consult your physician about any abnormal blood count results.
- Interpret values in context—age, sex, health status, and laboratory standards all matter.
- CBC results are starting points, not definitive answers. Confirm leukemia diagnoses with advanced tests.
References
- https://www.patientpower.info/navigating-cancer/leukemia-white-blood-cell-count
- https://www.healthline.com/health/leukemia/leukemia-white-blood-cell-count-range
- https://www.medicalnewstoday.com/articles/cml-leukemia-white-blood-cell-count-range
- https://www.myleukemiateam.com/resources/understanding-blood-counts-in-leukemia
- https://ada.com/white-blood-cell-count/
- https://my.clevelandclinic.org/health/body/21871-white-blood-cells
- https://leukemiarf.org/patients/diagnosis-testing/blood-tests/
- https://www.ucsfhealth.org/medical-tests/wbc-count
- https://www.hematology.org/about/history/50-years/chronic-myeloid-leukemia-therapy
Read full bio of medha deb










